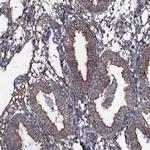
NEK1 Antibody in Immunohistochemistry (Paraffin) (IHC (P))

Search
Invitrogen
NEK1 Polyclonal Antibody
{{$productOrderCtrl.translations['antibody.pdp.commerceCard.promotion.promotions']}}
{{$productOrderCtrl.translations['antibody.pdp.commerceCard.promotion.viewpromo']}}
{{$productOrderCtrl.translations['antibody.pdp.commerceCard.promotion.promocode']}}: {{promo.promoCode}} {{promo.promoTitle}} {{promo.promoDescription}}. {{$productOrderCtrl.translations['antibody.pdp.commerceCard.promotion.learnmore']}}

Please note: We are reviewing Western blot images included in the antibody testing data in our catalog, including those provided by third parties. Unless expressly labeled or annotated as “raw-unedited”, Western blot images included in the antibody testing data in our catalog may have been edited, optimized or otherwise adjusted for presentation.
产品信息
PA5-59166
种属反应
宿主/亚型
分类
类型
抗原
偶联物
形式
浓度
规格
纯化类型
保存液
内含物
保存条件
运输条件
RRID
产品详细信息
Immunogen sequence: VLKEQLERKR KEAYEREKKV WEEHLVAKGV KSSDVSPPLG QHETGGSPSK QQMRSVISVT SALKEVGVDS SLTDTRETSE EMQKTNNAIS SKR
Highest antigen sequence identity to the following orthologs: Mouse - 81%, Rat - 80%.
靶标信息
NEK1 is a serine/threonine protein kinase, related to the NIMA cell cycle regulator, and is highly expressed in meiotic germ cells. The kinase may function early in the DNA damage response pathway. NEK1 may also participate in polycystic kidney disease and neural cell development. Like most members, the encoded protein contains an N-terminal pleckstrin homology domain and a highly conserved C-terminal OSBP-like sterol-binding domain.
仅用于科研。不用于诊断过程。未经明确授权不得转售。
篇参考文献 (0)
生物信息学
蛋白别名: DKFZp686D06121; DKFZp686K12169; MGC138800; Never in mitosis A-related kinase 1; NimA-related protein kinase 1; NY REN55; Renal carcinoma antigen NY-REN-55; Serine/threonine-protein kinase Nek1
基因别名: KIAA1901; NEK1
Entrez Gene ID: (Human) 4750




